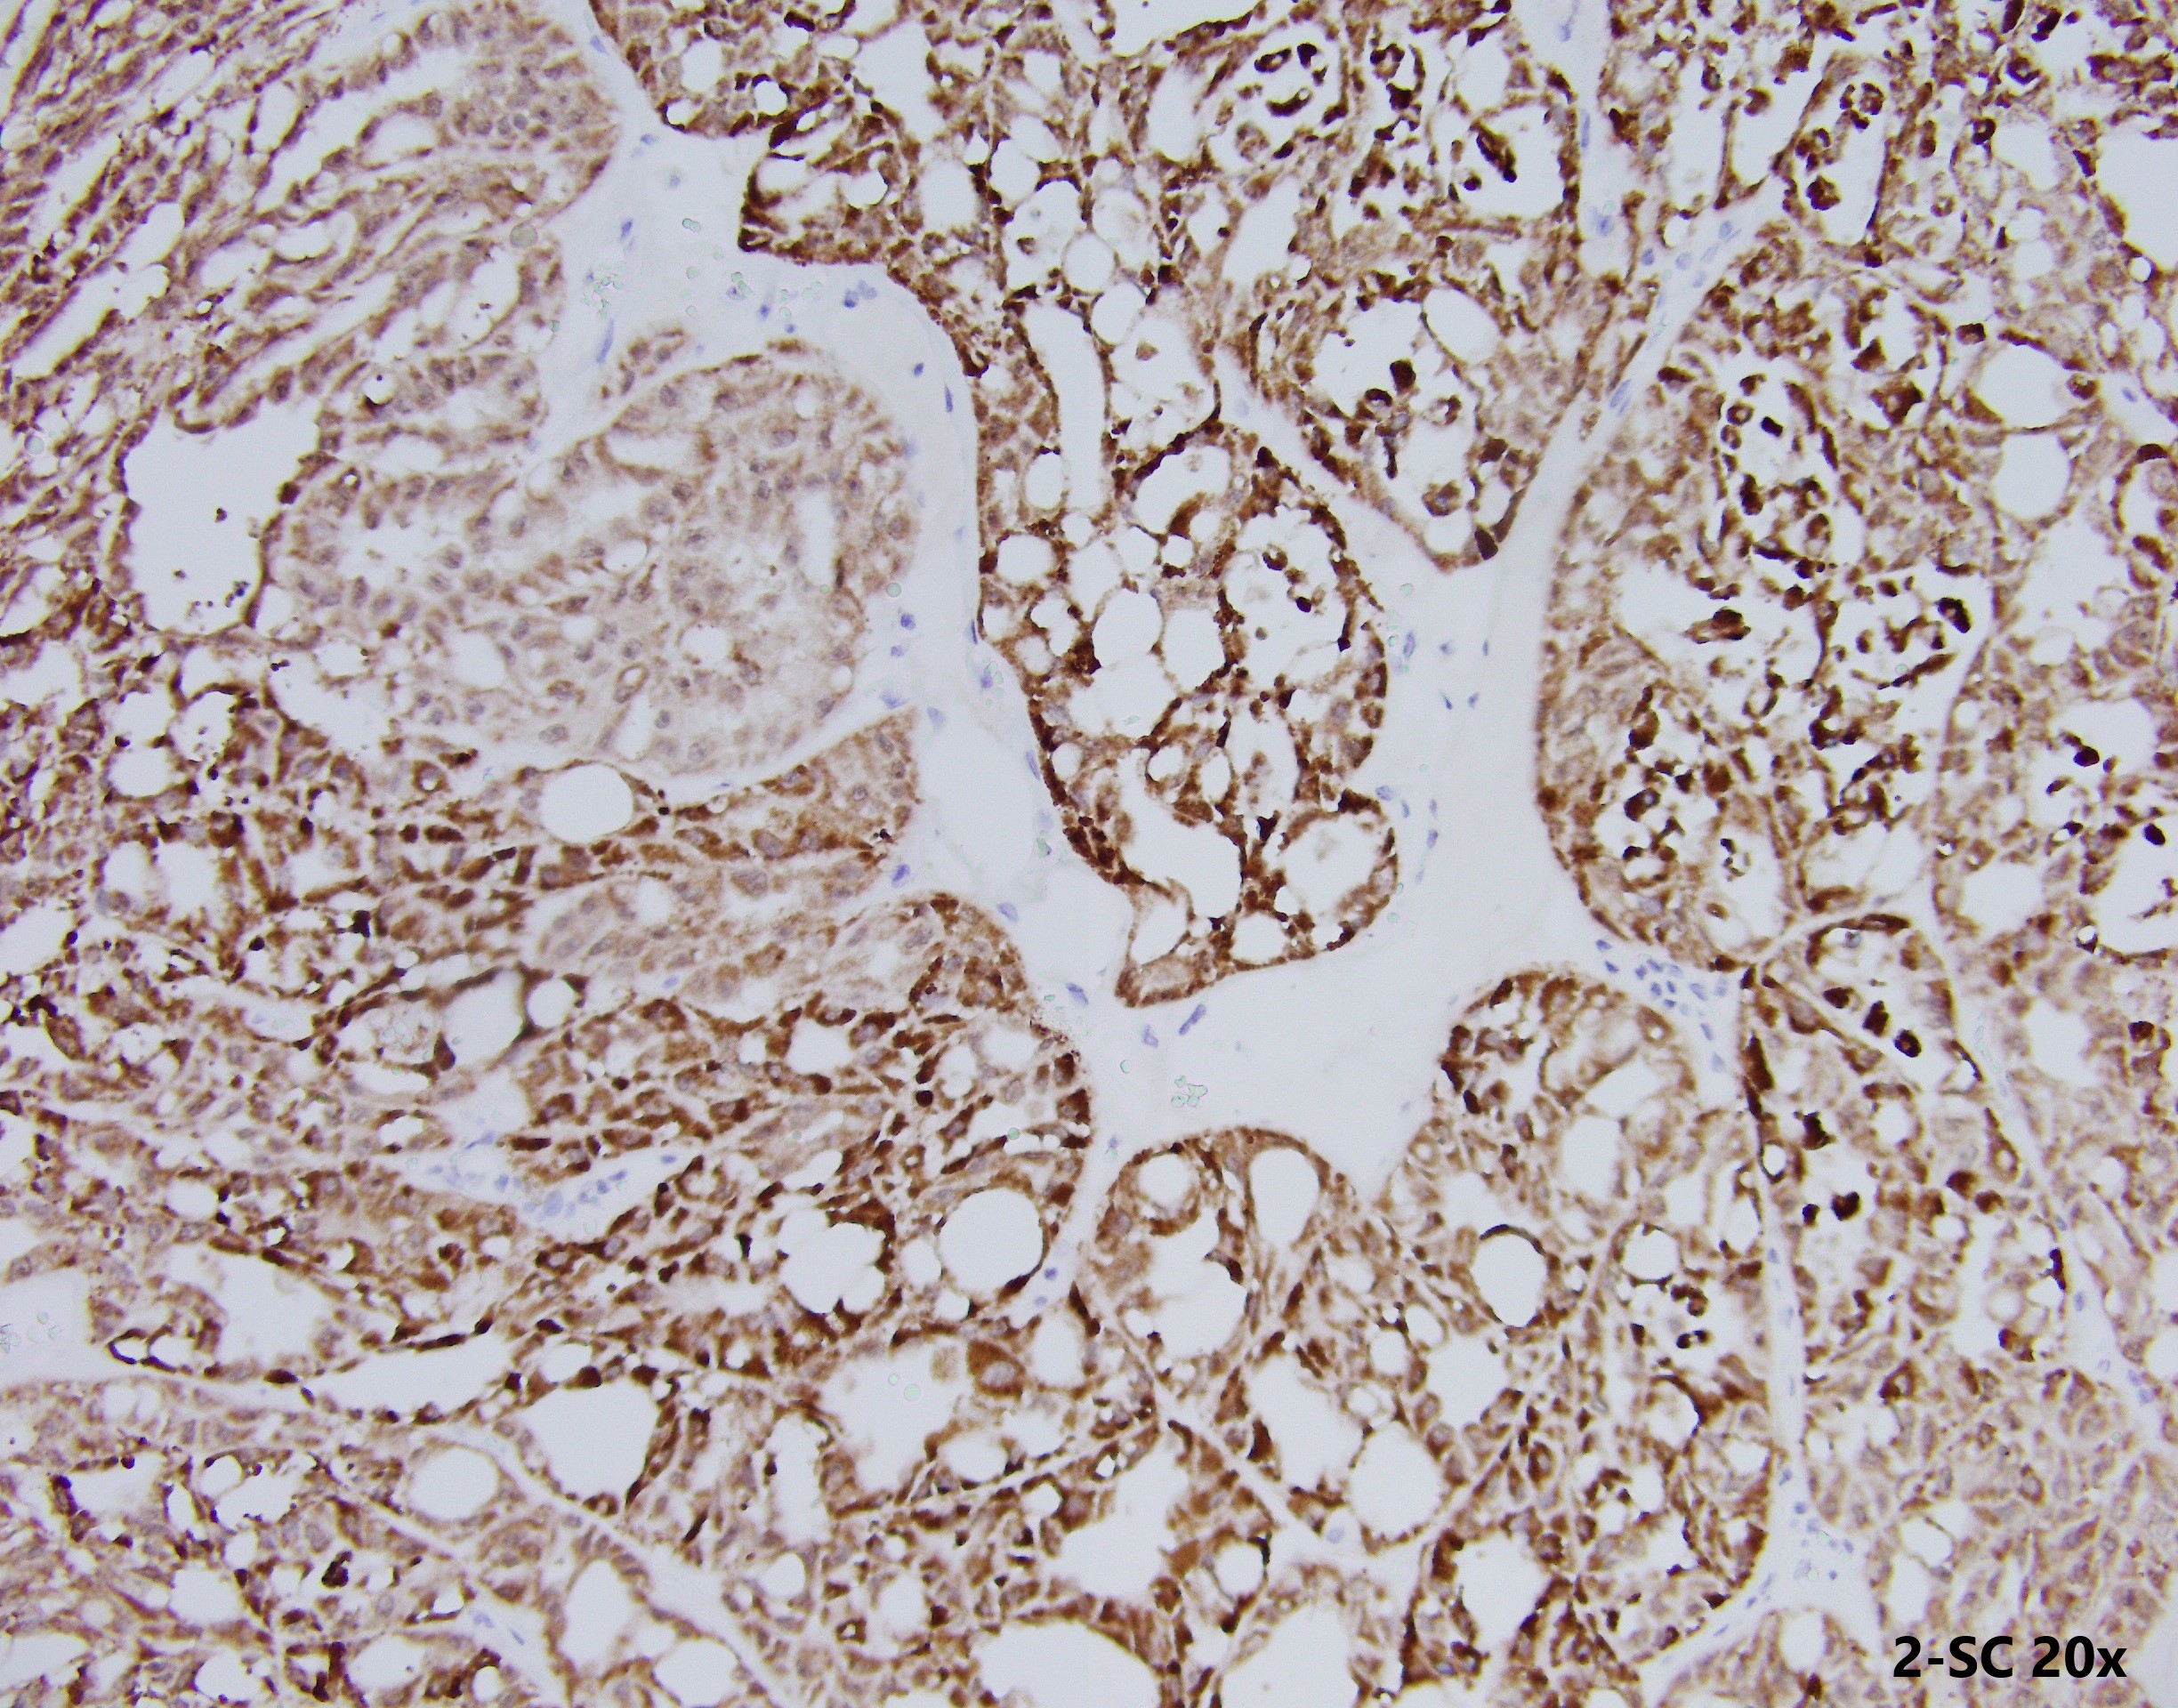

Case History
35 year-old-male with an 8 cm well-circumscribed, solid mass located in the upper pole of the left kidney with associated para-aortic metastasis. H&E, and IHC stains are shown.
Question #1: Based on H&E morphology, which is the least likely differential diagnosis?
- Papillary RCC type 2
- Collecting duct carcinoma
- Conventional clear cell RCC
- TFE3 translocation-associated RCC
Question #2: For a case with SDH-deficient RCC like morphology, also need to rule our FH-deficient RCC.
- True
- False
Question #3: Patient with FH germline mutation show consistently high frequency of high-grade RCC penetrance (>90%).
- True
- False

Discussion:
For question #1: “c” is the right answer.
Histologically, FH-deficient RCCs were originally described as type 2 papillary RCC and occasionally as collecting duct carcinoma (CDC), with a spectrum of architectural patterns including papillary, tubulopapillary, tubular, cribriform, solid and cystic elements. The morphological hallmarks of HLRCC are characteristic nuclear features: a large nucleus with a very prominent inclusion-like eosinophilic nucleolus surrounded by a perinucleolar halo. Based on these architectural and nuclear features, the differential diagnosis of HLRCC could include a variety of high-grade RCCs of different histological subtypes, particularly type 2 papillary RCC, CDC, or high-grade RCC, unclassified. Recently, an expanded histological spectrum of FH-deficient RCC has been described, including tubulocystic carcinoma with poorly differentiated foci, and SDH-deficient RCC like morphology was observed in FH-deficient RCC.
For question #2 and #3: The correct answers are “true” and “false” respectively.
Hereditary leiomyomatosis and renal cell carcinoma (HLRCC) is an entity in the WHO 2016 classification with germline mutation of fumarate hydratase (FH). HLRCC patients show high frequencies of cutaneous and uterine leiomyomatosis (>90%), with variably penetrant (estimated 5%–20%) high-grade RCC (choice a is not right). Some patients showing FH deficiency but lacking of genetic evidences of FH germline mutation are recognised as ‘FH-deficiency RCC’, somatic type. So choice b is right.
These tumours are characterised by negative immunohistochemistry for FH and aberrant succination of cellular proteins (2-succinylcysteine, 2SC). However, not all RCC show loss of FH stain by IHC (choice c is not right).
Although immunohistochemistry may provide rapid and effective evaluation of FH protein status, genetic testing is currently considered the criterion to diagnose HLRCC (choice d is not right).
Ref paper:
Pan X, et al. Fumaratehydratase-deficient renal cell carcinoma: a clinicopathological and molecular study of 13 cases. J Clin Pathol. 2019 Nov;72(11):748-754.